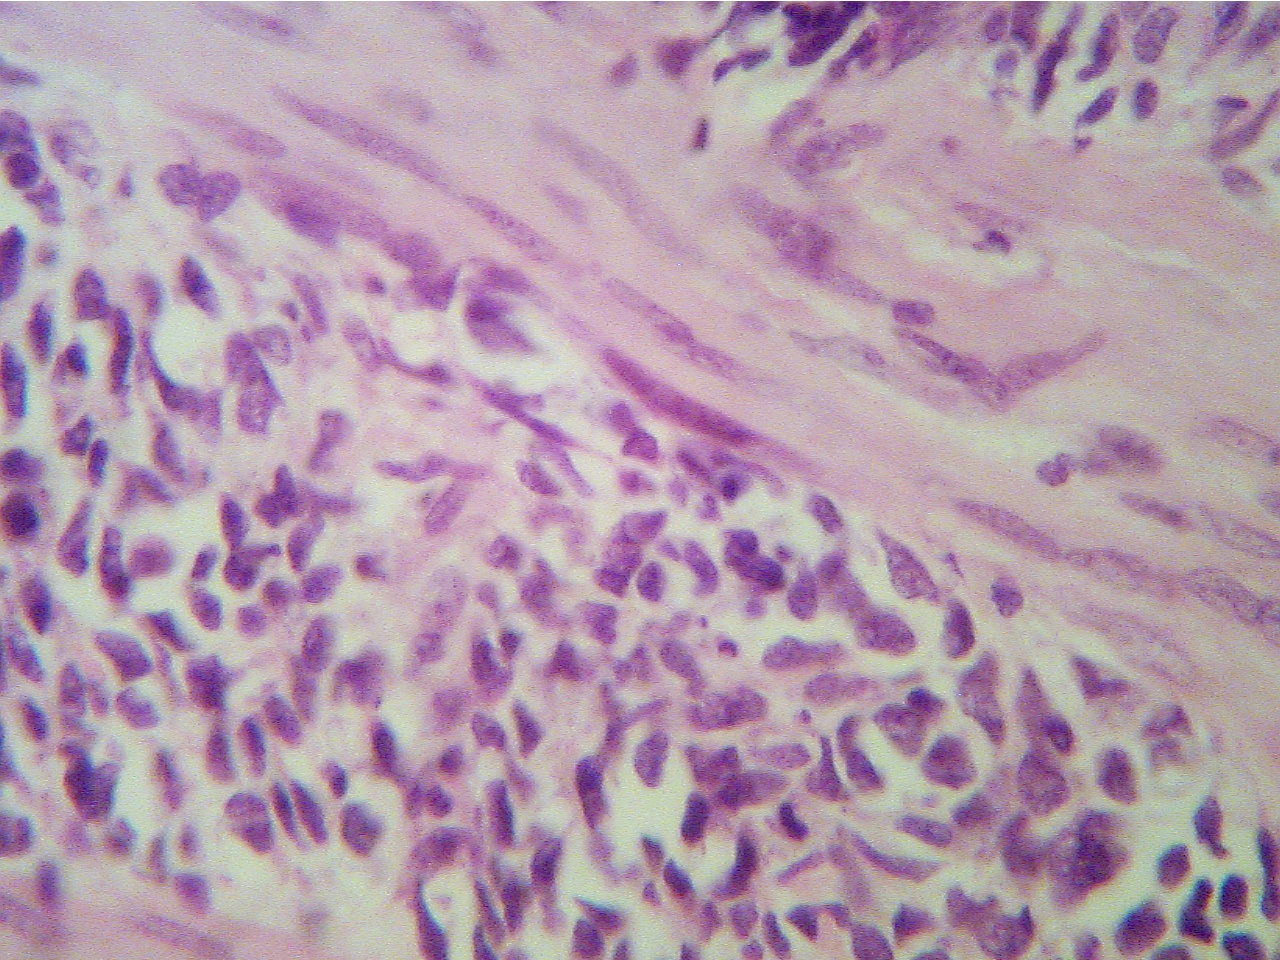

Return to Lab 01
Return to Slide List
Sarcoma - Sarcoma of the Uterus (PH 2007) (pp. 116-117)
(Be able to identify this
slide.)
Compare the normal and neoplastic cells in this slide of the uterine wall (myometrium). The normal smooth muscle cells are long, strap-like
(spindle-shaped) cells with oval nuclei and much pink cytoplasm. The neoplastic
cells are rounder, vary in size and have nuclei of various shapes and staining
intensities. These cells are anaplastic.
Sarcoma of the uterus (40X2.3)
Sarcoma of the uterus (100X2.0)


Pink smooth muscle and granular cancer
cells
Fibrous pink smooth muscle cells and many small blue
cancer cells
Sarcoma of the uterus (400X2.0)

Fibrous pink smooth muscle cells and many small blue
cancer cells
* What is meant by the term anaplastic?
Note that the neoplastic cells are invading into the normal tissue. There is
no sharp border between normal and neoplastic cells. Invasion into surrounding
normal tissue is one of the hallmark characteristics of a malignant neoplasm
(cancer).
* Name 5 other characteristics of malignancy.
* Why is this neoplasm called a sarcoma?
Return to Lab 01
Return to Slide List
8Copyright
2001 - Augustine G. DiGiovanna - All rights reserved.
This
material may not be reproduced or distributed in any form or by any means, or
stored in any data base or retrieval system without prior written permission is
obtained from Augustine G. DiGiovanna, Ph.D., Professor of Biology,
Salisbury University, Salisbury, MD 21801.